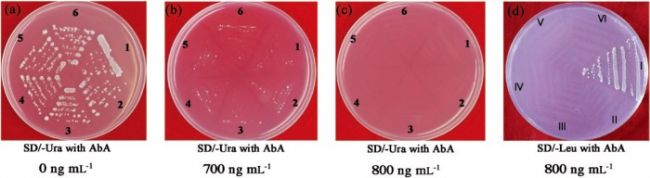

DAP-seq技術(shù)助力胡楊耐鹽機(jī)制的研究
瀏覽次數(shù):453 發(fā)布日期:2020-4-21
來源:本站 僅供參考,謝絕轉(zhuǎn)載,否則責(zé)任自負(fù)
2019年9月,北京林業(yè)大學(xué)和藍(lán)景科信合作,在植物學(xué)主流學(xué)術(shù)期刊Journal of Experimental Botany上(IF=5.36),發(fā)表了題為“Populus euphratica WRKY1 binds the promoter of H+-ATPase gene to enhance gene expression and salt tolerance”的研究成果。該研究借助DNA親和純化測(cè)序技術(shù)(DNA Affinity Purification Sequencing, DAP-seq),深入揭示了胡楊耐鹽的分子機(jī)制。
研究背景
胡楊(Populus euphratica Oliv.)是西北鹽堿荒漠地區(qū),唯一可以形成森林的高大喬木,是研究木本植物耐鹽分子和生理機(jī)制的模式樹種。但是胡楊的基因組相對(duì)復(fù)雜,高度雜合;而且,胡楊不容易建立遺傳轉(zhuǎn)化體系,研究難度大,亟需使用創(chuàng)新技術(shù)研究胡楊耐鹽的分子機(jī)制。
胡楊的耐鹽性高于其它種類的楊樹,鹽脅迫下,胡楊將Na+和Cl-區(qū)隔化到細(xì)胞的液泡中,限制NaCl向木質(zhì)部導(dǎo)管的裝載。胡楊能促進(jìn)Na+的外排、減少K+流失,維持離子平衡以降低鹽害。胡楊在長(zhǎng)期鹽脅迫下,能夠保持質(zhì)膜H+-ATPase的活性,從而具有較強(qiáng)的Na+/H+逆向轉(zhuǎn)運(yùn)能力。然而,胡楊質(zhì)膜H+-ATPase的轉(zhuǎn)錄與酶活調(diào)節(jié)機(jī)制并不清楚。本研究借助DAP-seq技術(shù),深入研究了PeWRKY1通過調(diào)控質(zhì)膜H+-ATPase PeHA1的表達(dá),參與胡楊耐鹽性形成的過程。
研究成果

圖1. 使用DAP-seq技術(shù)獲得PeWRKY1結(jié)合的motif。
圖2. 使用酵母單雜交技術(shù)驗(yàn)證PeWRKY1與
PeHA1啟動(dòng)子的互作。

圖3. 使用凝膠阻滯技術(shù)(Electrophoretic Mobility Shift Assay, EMSA)驗(yàn)證PeWRKY1與
PeHA1啟動(dòng)子中W-box的相互作用。

圖4. 使用熒光素酶檢測(cè)系統(tǒng)驗(yàn)證PeWRKY1與
PeHA1啟動(dòng)子的互作。
研究結(jié)論
本研究使用DAP-seq技術(shù),在基因組水平上,鑒定了PeWRKY1轉(zhuǎn)錄因子與胡楊基因組DNA的結(jié)合位點(diǎn)信息。并通過酵母單雜交、EMSA、熒光素酶檢測(cè)系統(tǒng)驗(yàn)證了這一結(jié)果。鹽脅迫促進(jìn)了PeWRKY1與PeHA1啟動(dòng)子區(qū)W-box的結(jié)合,從而提高了PeHA1的表達(dá)。PeWRKY1與PeHA1的相互作用,有助于增加質(zhì)膜H+-ATPase的活性、促進(jìn)Na+的排出,使胡楊在鹽脅迫下保持離子平衡。
關(guān)于DAP-seq
在基因組水平上,鑒定轉(zhuǎn)錄因子的結(jié)合位點(diǎn)(transcription factor binding sites, TFBS)非常重要。ChIP-seq是進(jìn)行體內(nèi)檢測(cè)TFBS的主要方法。然而,ChIP-seq依賴于抗體質(zhì)量,這對(duì)低表達(dá)的蛋白質(zhì)具有很大的挑戰(zhàn)性。所以,ChIP-seq通常在規(guī)模上受到限制,難以進(jìn)行高通量擴(kuò)展。因此,只有少數(shù)轉(zhuǎn)錄因子可以獲得結(jié)合位點(diǎn)信息,大量TFBS的覆蓋范圍僅適用于人類和一些模式生物。
DAP-seq具有與ChIP-seq同樣的功能。通過體外蛋白表達(dá)技術(shù),表達(dá)出帶有標(biāo)簽的轉(zhuǎn)錄因子,和基因組DNA文庫在體外進(jìn)行結(jié)合,然后分離出所有與轉(zhuǎn)錄因子結(jié)合的DNA,再使用高通量測(cè)序,找到轉(zhuǎn)錄因子的結(jié)合位點(diǎn)。
DAP-seq的優(yōu)勢(shì)
與ChIP-seq相比,DAP-seq不需要針對(duì)每個(gè)轉(zhuǎn)錄因子制備特異性抗體。具有快速、高通量、節(jié)約時(shí)間成本的優(yōu)勢(shì),并且適用于所有的真核生物。
藍(lán)景科信提供DAP-seq全流程技術(shù)服務(wù)+個(gè)性化數(shù)據(jù)分析,與中國科學(xué)院、中國農(nóng)業(yè)科學(xué)院、中國林業(yè)科學(xué)研究院、浙江大學(xué)、中國農(nóng)業(yè)大學(xué)、華中農(nóng)業(yè)大學(xué)、北京林業(yè)大學(xué)、河北農(nóng)業(yè)大學(xué)等多個(gè)科研院所合作,具有豐富的技術(shù)服務(wù)經(jīng)驗(yàn)。已經(jīng)做過的材料包括:擬南芥,水稻,小麥,玉米,大豆,苜蓿,百脈根,菜心,棗,荔枝,香蕉,毛果楊,胡楊,油松。